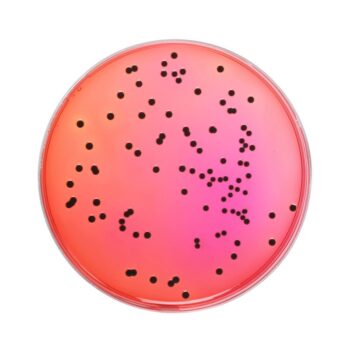
HiMedia GM031 - distributed by Immunomart

-
XA Selective Supplement 154 CADFor Research Use Only. Not for human or animal consumption, therapeutic, or diagnostic use.
Hi-Media catalog product. XA Selective Supplement.
For Research Use Only (RUO). Not for human or veterinary consumption, therapeutic, or diagnostic use.
-
XLD Agar 70 CAD – 211 CADPrice range: 70 CAD through 211 CADFor Research Use Only. Not for human or animal consumption, therapeutic, or diagnostic use.
Hi-Media catalog product. XLD Agar. Available in 2 sizes.
For Research Use Only (RUO). Not for human or veterinary consumption, therapeutic, or diagnostic use.
-
XLD Agar Modified 221 CAD – 2,002 CADPrice range: 221 CAD through 2,002 CADFor Research Use Only. Not for human or animal consumption, therapeutic, or diagnostic use.
Hi-Media catalog product. XLD Agar Modified. Available in 3 sizes.
For Research Use Only (RUO). Not for human or veterinary consumption, therapeutic, or diagnostic use.
-
XLD Agar, Modified, Granulated 283 CADFor Research Use Only. Not for human or animal consumption, therapeutic, or diagnostic use.
Hi-Media catalog product. XLD Agar, Modified, Granulated.
For Research Use Only (RUO). Not for human or veterinary consumption, therapeutic, or diagnostic use.
-
XLD HiVeg Agar 82 CAD – 1,912 CADPrice range: 82 CAD through 1,912 CADFor Research Use Only. Not for human or animal consumption, therapeutic, or diagnostic use.
Hi-Media catalog product. XLD HiVeg Agar. Available in 4 sizes.
For Research Use Only (RUO). Not for human or veterinary consumption, therapeutic, or diagnostic use.
-
XLT4 Agar Base 685 CAD – 2,616 CADPrice range: 685 CAD through 2,616 CADFor Research Use Only. Not for human or animal consumption, therapeutic, or diagnostic use.
Hi-Media catalog product. XLT4 Agar Base. Available in 3 sizes.
For Research Use Only (RUO). Not for human or veterinary consumption, therapeutic, or diagnostic use.
-
XLT4 HiVeg Agar Base 310 CAD – 2,725 CADPrice range: 310 CAD through 2,725 CADFor Research Use Only. Not for human or animal consumption, therapeutic, or diagnostic use.
Hi-Media catalog product. XLT4 HiVeg Agar Base. Available in 3 sizes.
For Research Use Only (RUO). Not for human or veterinary consumption, therapeutic, or diagnostic use.
-
XLT4 Supplement 186 CADFor Research Use Only. Not for human or animal consumption, therapeutic, or diagnostic use.
Hi-Media catalog product. XLT4 Supplement.
For Research Use Only (RUO). Not for human or veterinary consumption, therapeutic, or diagnostic use.
-
Xylose Lysine Agar Base 74 CAD – 2,002 CADPrice range: 74 CAD through 2,002 CADFor Research Use Only. Not for human or animal consumption, therapeutic, or diagnostic use.
Hi-Media catalog product. Xylose Lysine Agar Base. Available in 4 sizes.
For Research Use Only (RUO). Not for human or veterinary consumption, therapeutic, or diagnostic use.
-
Xylose Lysine Deoxycholate Agar 274 CAD – 2,392 CADPrice range: 274 CAD through 2,392 CADFor Research Use Only. Not for human or animal consumption, therapeutic, or diagnostic use.
Hi-Media catalog product. Xylose Lysine Deoxycholate Agar. Available in 3 sizes.
For Research Use Only (RUO). Not for human or veterinary consumption, therapeutic, or diagnostic use.
Proudly representing





150+ years of combined research-supply heritage